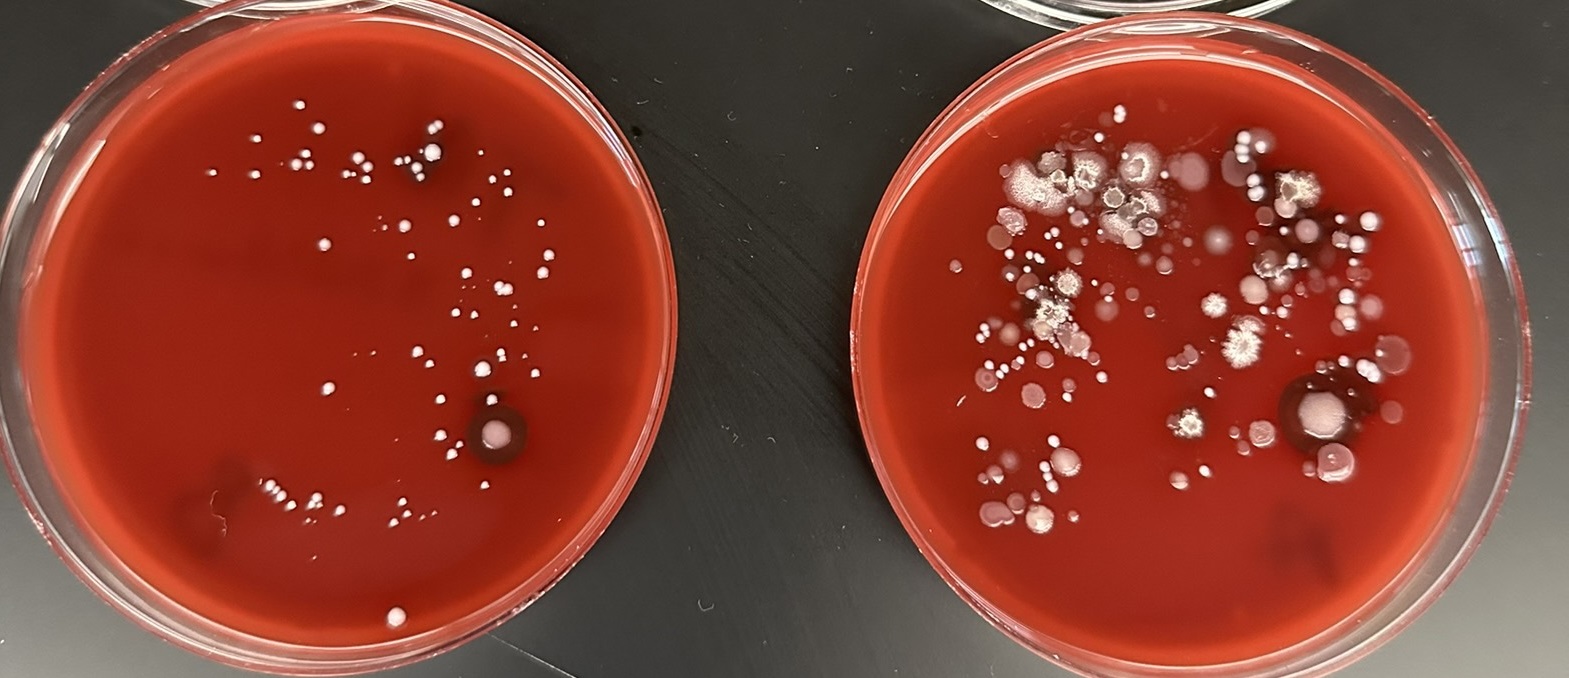

Biology B.S., Microbiology Concentration
The Microbiology concentration delves into the study of microorganisms, including bacteria, viruses, fungi, and protozoa. Students gain knowledge in areas such as diagnostic microbiology, microbial genomics, host-microbe interactions, immunology, and applied microbiology, preparing them for advanced research and practical applications in microbiology.
Microbiology graduates can pursue careers in medical and environmental microbiology, biotechnology, pharmaceuticals, and public health. They work as lab technicians, research scientists, and in roles related to disease control, food safety, plant microbiology, and environmental monitoring.
Career Opportunities and Estimated Salaries:
- Medical Microbiologist: $60,000 - $100,000 per year
- Environmental Microbiologist: $50,000 - $80,000 per year
- Biotechnologist: $60,000 - $90,000 per year
- Public Health Microbiologist: $50,000 - $70,000 per year